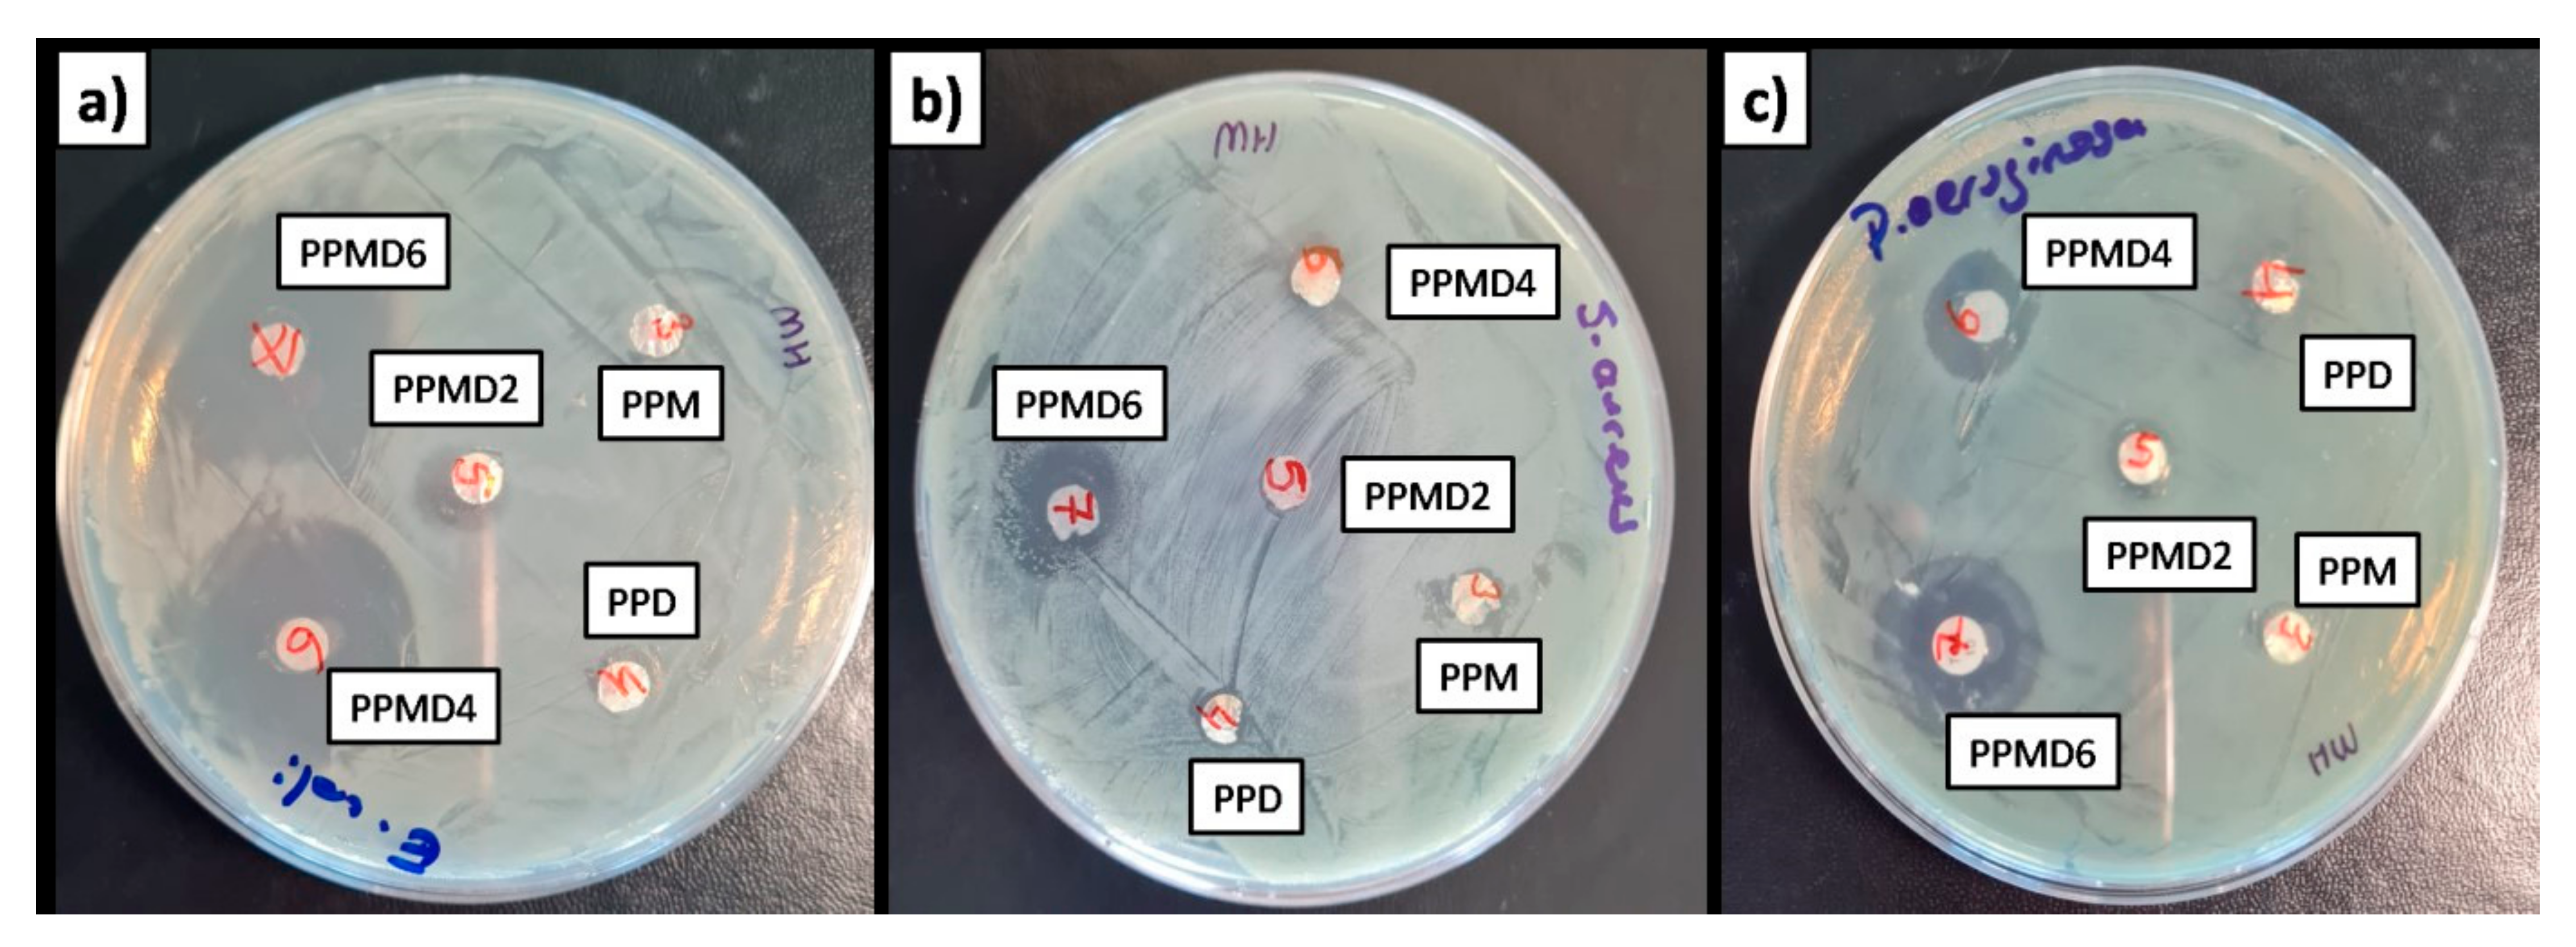
Polymers 14 01490 g010

Development of PVA–Psyllium Husk Meshes via Emulsion Electrospinning: Preparation, Characterization, and Antibacterial Activity
Abstract
:1. Introduction
2. Materials and Methods
2.1. Materials
2.2. Preparation of Modified Microcrystalline Cellulose
2.3. Fabrication of Polysaccharide Nanofibers
2.4. Characterization
2.5. In Vitro Release Study
2.6. Antimicrobial Efficiency
3. Results and Discussion
3.1. Microstructure and Morphological Analysis
3.2. FT-IR Analysis
3.3. Thermal Stability Test
3.4. In Vitro Release Study
3.5. Contact Angle Analysis
3.6. Antibacterial Assays
4. Conclusions
Author Contributions
Funding
Data Availability Statement
Conflicts of Interest
References
- Nussbaum, S.R.; Carter, M.J.; Fife, C.E.; DaVanzo, J.; Haught, R.; Nusgart, M.; Cartwright, D. An Economic Evaluation of the Impact, Cost, and Medicare Policy Implications of Chronic Nonhealing Wounds. Value Health 2018, 21, 27–32. [Google Scholar] [CrossRef] [PubMed] [Green Version]
- He, M.; Ou, F.; Wu, Y.; Sun, X.; Chen, X.; Li, H.; Sun, D.; Zhang, L. Smart multi-layer PVA foam/CMC mesh dressing with integrated multi-functions for wound management and infection monitoring. Mater. Des. 2020, 194, 108913. [Google Scholar] [CrossRef]
- Sen, C.K. Human Wounds and Its Burden: An Updated Compendium of Estimates. Adv. Wound Care 2019, 8, 39–48. [Google Scholar] [CrossRef] [PubMed] [Green Version]
- Phan, D.; Khan, M.Q.; Nguyen, V.; Vu-manh, H.; Dao, A.; Thao, P.T.; Nguyen, N.; Le, V.; Ullah, A.; Khatri, M.; et al. Investigation of Mechanical, Chemical, and Antibacterial Properties of Electrospun Cellulose-Based Scaffolds Containing Orange Essential Oil and Silver Nanoparticles. Polymers 2022, 14, 85. [Google Scholar] [CrossRef] [PubMed]
- Haider, K.; Sun, L.; Ullah, A.; Ullah, S.; Suzuki, Y.; Park, S.; Kato, Y.; Tamada, Y.; Kim, I.-S. Polyacrylonitrile/Carbon Black nanoparticle/Nano-Hydroxyapatite (PAN/nCB/HA) composite nanofibrous matrix as a potential biomaterial scaffold for bone regenerative applications. Mater. Today Commun. 2021, 27, 102259. [Google Scholar] [CrossRef]
- Umar, M.; Ullah, A.; Nawaz, H.; Areeb, T.; Hashmi, M.; Kharaghani, D.; Kim, K.O.; Kim, I.S. Wet-spun bi-component alginate based hydrogel fibers: Development and in-vitro evaluation as a potential moist wound care dressing. Int. J. Biol. Macromol. 2021, 168, 601–610. [Google Scholar] [CrossRef]
- Ullah, A.; Ullah, S.; Areeb, T.; Umar, M.; Nam, P.D.; Masood, R.; Park, S.; Kim, I.S. An Experimental Study on Modelling the Physical Properties of Composite Psyllium, Alginate and Chitosan Fibers Using Box-Behnken Technique. Fibers Polym. 2020, 21, 2494–2504. [Google Scholar] [CrossRef]
- Parın, F.N.; Parın, U. Spirulina Biomass-Loaded Thermoplastic Polyurethane/Polycaprolacton (TPU/PCL) Nanofibrous Mats: Fabrication, Characterization, and Antibacterial Activity as Potential Wound Healing. ChemistrySelect 2022, 7, e202104148. [Google Scholar] [CrossRef]
- Mamidi, N.; Velasco Delgadillo, R.M.; Barrera, E.V. Covalently functionalized carbon nano-onions integrated gelatin methacryloyl nanocomposite hydrogel containing γ-cyclodextrin as drug carrier for high-performance ph-triggered drug release. Pharmaceuticals 2021, 14, 291. [Google Scholar] [CrossRef]
- Mamidi, N.; Delgadillo, R.M.V.; González-Ortiz, A. Engineering of carbon nano-onion bioconjugates for biomedical applications. Mater. Sci. Eng. C 2021, 120, 111698. [Google Scholar] [CrossRef]
- Mamidi, N.; Villela Castrejón, J.; González-Ortiz, A. Rational design and engineering of carbon nano-onions reinforced natural protein nanocomposite hydrogels for biomedical applications. J. Mech. Behav. Biomed. Mater. 2020, 104, 103696. [Google Scholar] [CrossRef] [PubMed]
- Mamidi, N.; González-Ortiz, A.; Romo, I.L.; Barrera, E.V. Development of functionalized carbon nano-onions reinforced zein protein hydrogel interfaces for controlled drug release. Pharmaceutics 2019, 11, 621. [Google Scholar] [CrossRef] [PubMed] [Green Version]
- Mamidi, N.; Zuníga, A.E.; Villela-Castrejón, J. Engineering and evaluation of forcespun functionalized carbon nano-onions reinforced poly (ε-caprolactone) composite nanofibers for pH-responsive drug release. Mater. Sci. Eng. C 2020, 112, 110928. [Google Scholar] [CrossRef] [PubMed]
- Hussain, T.; Masood, R.; Umar, M.; Areeb, T.; Ullah, A. Development and characterization of alginate-chitosan-hyaluronic acid (ACH) composite fibers for medical applications. Fibers Polym. 2016, 17, 1749–1756. [Google Scholar] [CrossRef]
- Masood, R.; Hussain, T.; Umar, M.; Ullah, A.; Areeb, T.; Riaz, S. In situ development and application of natural coatings on non absorbable sutures to reduce incision site infections. J. Wound Care 2017, 457, 115–120. [Google Scholar] [CrossRef]
- Kim, M.O.; Khan, M.Q.; Ullah, A.; Duy, N.P.; Zhu, C.; Lee, J.S.; Kim, I.S. Development of VOCs gas sensor with high sensitivity using colorimetric polymer nanofiber: A unique sensing method. Mater. Res. Express 2019, 6, 105372. [Google Scholar] [CrossRef]
- Bie, X.; Khan, M.Q.; Ullah, A.; Ullah, S.; Kharaghani, D.; Phan, D.N.; Tamada, Y.; Kim, I.S. Fabrication and characterization of wound dressings containing gentamicin/silver for wounds in diabetes mellitus patients. Mater. Res. Express 2020, 7, 045004. [Google Scholar] [CrossRef]
- Mouro, C.; Gomes, A.P.; Ahonen, M.; Fangueiro, R.; Gouveia, I.C. Chelidoniummajus L. Incorporated Emulsion Electrospun PCL/PVA_PEC Nanofibrous Meshes for Antibacterial Wound Dressing Applications. Nanomaterials 2021, 11, 1785. [Google Scholar] [CrossRef] [PubMed]
- Bardoňová, L.; Kotzianová, A.; Skuhrovcová, K.; Židek, O.; Vágnerová, H.; Kulhánek, J.; Hanová, T.; Knor, M.; Starigazdová, J.; Mamulová Kutláková, K.; et al. Effects of emulsion, dispersion, and blend electrospinning on hyaluronic acid nanofibers with incorporated antiseptics. Int. J. Biol. Macromol. 2022, 194, 726–735. [Google Scholar] [CrossRef] [PubMed]
- Parın, F.N.; Yıldırım, K. Preparation and characterisation of vitamin-loaded electrospun nanofibres as promising transdermal patches. Fibres Text. East. Eur. 2021, 29, 17–25. [Google Scholar] [CrossRef]
- Fatma Nur, P.; Pınar, T.; Uğur, P.; Ayşenur, Y.; Murat, E.; Kenan, Y. Fabrication of polyamide 6/honey/boric acid mats by electrohydrodynamic processes for wound healing applications. Mater. Today Commun. 2021, 29, 2–11. [Google Scholar] [CrossRef]
- Parın, F.N.; Aydemir, Ç.İ.; Taner, G.; Yıldırım, K. Co-electrospun-electrosprayed PVA/folic acid nanofibers for transdermal drug delivery: Preparation, characterization, and in vitro cytocompatibility. J. Ind. Text. 2021. [Google Scholar] [CrossRef]
- Shin, J.; Lee, S. Encapsulation of Phytoncide in Nanofibers by Emulsion Electrospinning and their Antimicrobial Assessment. Fibers Polym. 2018, 19, 627–634. [Google Scholar] [CrossRef]
- Cengiz Çallıoğlu, F.; Kesici Güler, H. Production of Essential Oil-Based Composite Nanofibers by Emulsion Electrospinning. Pamukkale Univ. J. Eng. Sci. 2020, 26, 1178–1185. [Google Scholar] [CrossRef]
- Rieger, K.A.; Birch, N.P.; Schiffman, J.D. Electrospinning chitosan/poly(ethylene oxide) solutions with essential oils: Correlating solution rheology to nanofiber formation. Carbohydr. Polym. 2016, 139, 131–138. [Google Scholar] [CrossRef]
- Lamarra, J.; Calienni, M.N.; Rivero, S.; Pinotti, A. Electrospun nanofibers of poly(vinyl alcohol) and chitosan-based emulsions functionalized with cabreuva essential oil. Int. J. Biol. Macromol. 2020, 160, 307–318. [Google Scholar] [CrossRef] [PubMed]
- Mouro, C.; Simões, M.; Gouveia, I.C. Emulsion Electrospun Fiber Mats of PCL/PVA/Chitosan and Eugenol for Wound Dressing Applications. Adv. Polym. Technol. 2019, 2019, 9859506. [Google Scholar] [CrossRef] [Green Version]
- Ullah, A.; Haider, K.; Wang, F.; Morita, S.; Kharaghani, D.; Ge, Y.; Yoshiko, Y.; Soon, J.; Soo, I. “Clay-corn-caprolactone” a novel bioactive clay polymer nanofibrous scaffold for bone tissue engineering. Appl. Clay Sci. 2022, 220, 106455. [Google Scholar] [CrossRef]
- Zhang, W.; Ronca, S.; Mele, E. Electrospun Nanofibres Containing Antimicrobial Plant Extracts. Nanomaterials 2017, 7, 42. [Google Scholar] [CrossRef] [PubMed] [Green Version]
- Nikmaram, N.; Roohinejad, S.; Hashemi, S.; Koubaa, M.; Barba, F.J.; Abbaspourrad, A.; Greiner, R. Emulsion-based systems for fabrication of electrospun nanofibers: Food, pharmaceutical and biomedical applications. RSC Adv. 2017, 7, 28951–28964. [Google Scholar] [CrossRef] [Green Version]
- Ullah, A.; Saito, Y.; Ullah, S.; Haider, M.K.; Nawaz, H.; Duy-Nam, P.; Kharaghani, D.; Kim, I.S. Bioactive Sambong oil-loaded electrospun cellulose acetate nanofibers: Preparation, characterization, and in-vitro biocompatibility. Int. J. Biol. Macromol. 2021, 166, 1009–1021. [Google Scholar] [CrossRef]
- Choi, H.S. Lipolytic effects of citrus peel oils and their components. J. Agric. Food Chem. 2006, 54, 3254–3258. [Google Scholar] [CrossRef] [PubMed]
- Miller, J.A.; Thompson, P.A.; Hakim, I.A.; Chow, H.H.S.; Thomson, C.A. D-Limonene: A bioactive food component from citrus and evidence for a potential role in breast cancer prevention and treatment. Oncol. Rev. 2011, 5, 31–42. [Google Scholar] [CrossRef]
- Anandakumar, P.; Kamaraj, S.; Vanitha, M.K. D-limonene: A multifunctional compound with potent therapeutic effects. J. Food Biochem. 2021, 45, e13566. [Google Scholar] [CrossRef] [PubMed]
- Hsouna, A.B.; Trigui, M.; Mansour, R.B.; Jarraya, R.M.; Damak, M.; Jaoua, S. Chemical composition, cytotoxicity effect and antimicrobial activity of Ceratonia siliqua essential oil with preservative effects against Listeria inoculated in minced beef meat. Int. J. Food Microbiol. 2011, 148, 66–72. [Google Scholar] [CrossRef] [PubMed]
- Kim, Y.W.; Kim, M.J.; Chung, B.Y.; Bang, D.Y.; Lim, S.K.; Choi, S.M.; Lim, D.S.; Cho, M.C.; Yoon, K.; Kim, H.S.; et al. Safety Evaluation and Risk Assessment of d-Limonene. J. Toxicol. Environ. Health—Part B Crit. Rev. 2013, 16, 17–38. [Google Scholar] [CrossRef]
- Han, Y.; Sun, Z.; Chen, W. Antimicrobial Susceptibility and Antibacterial Mechanism of Limonene against Listeria monocytogenes. Molecules 2020, 25, 33. [Google Scholar] [CrossRef] [Green Version]
- Mustafa Evren, B.T. Uçucu Yağların Antimikrobiyel Özellikleri. Elektronik Mikrobiyoloji Dergisi 2011, 9, 28–40. [Google Scholar]
- Gönülşen, I.; Sariişik, M.; Erkan, G.; Okur, S. Portakal Yağı İçeren Mikro ve Moleküler Kapsül Aktarılmış Kumaşlardan Salım Davranışlarının İncelenmesi. Tekstil ve Mühendis 2016, 23, 22–33. [Google Scholar] [CrossRef]
- Fuenmayor, C.A.; Mascheroni, E.; Cosio, M.S.; Piergiovanni, L.; Benedetti, S.; Ortenzi, M.; Schiraldi, A.; Mannino, S. Encapsulation of R-(+)-limonene in edible electrospun nanofibers. Chem. Eng. Trans. 2013, 32, 1771–1776. [Google Scholar] [CrossRef]
- Söğüt, E.; Seydim, A.C. D-Limonen ve Nanoselüloz İçeren Aktif Kitosan/Polikaprolakton İki Katmanlı Filmler. Süleyman Demirel Üniversitesi Fen Bilimleri Enstitüsü Dergisi 2020, 24, 618–625. [Google Scholar] [CrossRef]
- Lan, W.; Liang, X.; Lan, W.; Ahmed, S.; Liu, Y.; Qin, W. Electrospun Polyvinyl Alcohol/d-Limonene Fibers Prepared by Ultrasonic Processing for Antibacterial Active Packaging Material. Molecules 2019, 24, 767. [Google Scholar] [CrossRef] [Green Version]
- Masood, R.; Hussain, T.; Miraftab, M.; Ali Raza, Z.; Ullah, A.; Areeb, T.; Umar, M.; Riaz, R. Development of tri-component antibacterial hybrid fibres for potential use in wound care. J. Wound Care 2018, 27, 394–402. [Google Scholar] [CrossRef] [PubMed]
- Masood, R.; Hussain, T.; Miraftab, M.; Ullah, A.; Raza, Z.A.; Areeb, T.; Umar, M. Novel alginate, chitosan, and psyllium composite fiber for wound-care applications. J. Ind. Text. 2017, 47, 20–37. [Google Scholar] [CrossRef]
- Rafieian, F.; Mousavi, M.; Yu, Q.; Jonoobi, M. Amine functionalization of microcrystalline cellulose assisted by (3-chloropropyl)triethoxysilane. Int. J. Biol. Macromol. 2019, 130, 280–287. [Google Scholar] [CrossRef] [PubMed]
- Ullah, A.; Ullah, S.; Khan, M.Q.; Hashmi, M.; Nam, P.D.; Kato, Y.; Tamada, Y.; Kim, I.S. Manuka honey incorporated cellulose acetate nanofibrous mats: Fabrication and in vitro evaluation as a potential wound dressing. Int. J. Biol. Macromol. 2020, 155, 479–489. [Google Scholar] [CrossRef]
- Amariei, N.; Manea, L.R.; Bertea, A.P.; Bertea, A.; Popa, A. The Influence of Polymer Solution on the Properties of Electrospun 3D Nanostructures. IOP Conf. Ser. Mater. Sci. Eng. 2017, 209, 012092. [Google Scholar] [CrossRef] [Green Version]
- De Oliveira Mori, C.L.S.; dos Passos, N.A.; Oliveira, J.E.; Altoé, T.F.; Mori, F.A.; Mattoso, L.H.C.; Scolforo, J.R.; Tonoli, G.H.D. Nanostructured polylactic Acid/candeia essential oil mats obtained by electrospinning. J. Nanomater. 2015, 16, 33. [Google Scholar] [CrossRef]
- Kalita, R.D.; Nath, Y.; Ochubiojo, M.E.; Buragohain, A.K. Extraction and characterization of microcrystalline cellulose from fodder grass; Setaria glauca (L.) P. Beauv, and its potential as a drug delivery vehicle for isoniazid, a first line antituberculosis drug. Colloids Surf. B Biointerfaces 2013, 108, 85–89. [Google Scholar] [CrossRef] [PubMed]
- Sharma, V.K.; Mazumder, B. Crosslinking of Isabgol husk polysaccharides for microspheres development and its impact on particle size, swelling kinetics and thermal behavior. Polym. Bull. 2014, 71, 735–757. [Google Scholar] [CrossRef]
- Salehi, O.; Sami, M.; Rezaei, A. Limonene loaded cyclodextrin nanosponge: Preparation, characterization, antibacterial activity and controlled release. Food Biosci. 2021, 42, 101193. [Google Scholar] [CrossRef]
- Tang, Y.; Liu, Z.; Zhao, K.; Fu, S. Adsorption and separation properties of positively charged ZrO2 nanofibrous membranes fabricated by electrospinning. RSC Adv. 2017, 7, 42505–42512. [Google Scholar] [CrossRef] [Green Version]
- Ardekani, N.T.; Khorram, M.; Zomorodian, K.; Yazdanpanah, S.; Veisi, H.; Veisi, H. Evaluation of electrospun poly (vinyl alcohol)-based nanofiber mats incorporated with Zataria multiflora essential oil as potential wound dressing. Int. J. Biol. Macromol. 2019, 125, 743–750. [Google Scholar] [CrossRef]
- Luraghi, A.; Peri, F.; Moroni, L. Electrospinning for drug delivery applications: A review. J. Control Release 2021, 334, 463–484. [Google Scholar] [CrossRef]
- Aadil, K.R.; Nathani, A.; Sharma, C.S.; Lenka, N.; Gupta, P. Fabrication of biocompatible alginate-poly(vinyl alcohol) nanofibers scaffolds for tissue engineering applications. Mater. Technol. 2018, 33, 507–512. [Google Scholar] [CrossRef]
- Moyers-Montoya, E.; García-Casillas, P.; Vargas-Requena, C.; Escobedo-González, R.; Martel-Estrada, S.A.; Martínez-Pérez, C.A. Polycaprolactone/Amino-β-Cyclodextrin Inclusion Complex Prepared by an Electrospinning Technique. Polymers 2016, 8, 395. [Google Scholar] [CrossRef] [PubMed] [Green Version]
- Mohamadi, P.S.; Hivechi, A.; Bahrami, H.; Hemmatinegad, N.; Milan, P.B. Antibacterial and biological properties of coconut oil loaded poly(ε-caprolactone)/gelatin electrospun membranes. J. Ind. Text. 2021, 1–25. [Google Scholar] [CrossRef]
- Ahmad, D.; van den Boogaert, I.; Miller, J.; Presswell, R.; Jouhara, H. Hydrophilic and hydrophobic materials and their applications. Energy Sources Part A Recovery Util. Environ. Eff. 2018, 40, 2686–2725. [Google Scholar] [CrossRef]
- Haider, M.K.; Ullah, A.; Sarwar, M.N.; Saito, Y.; Sun, L.; Park, S.; Kim, I.S. Lignin-mediated in-situ synthesis of CuO nanoparticles on cellulose nanofibers: A potential wound dressing material. Int. J. Biol. Macromol. 2021, 173, 315–326. [Google Scholar] [CrossRef] [PubMed]
- Junker, J.P.E.; Kamel, R.A.; Caterson, E.J.; Eriksson, E. Clinical Impact Upon Wound Healing and Inflammation in Moist, Wet, and Dry Environments. Adv. Wound Care 2013, 2, 348–356. [Google Scholar] [CrossRef] [Green Version]
- Eddin, L.B.; Jha, N.K.; Meeran, M.F.N.; Kesari, K.K.; Beiram, R.; Ojha, S. Neuroprotective Potential of Limonene and Limonene Containing Natural Products. Molecules 2021, 26, 4535. [Google Scholar] [CrossRef] [PubMed]
- Gerhardt, C.; Wiest, J.M.; Girolometto, G.; da Silva, M.A.S.; Weschenfelder, S. Aproveitamento da casca de citros na perspectiva de alimentos: Prospecção da atividade antibacteriana. Braz. J. Food Technol. 2012, 15, 11–17. [Google Scholar] [CrossRef]
- Da Silva, C.F.; de Oliveira, F.S.M.; Caetano, V.F.; Vinhas, G.M.; Cardoso, S.A. Orange essential oil as antimicrobial additives in poly(vinyl chloride) films. Polimeros 2018, 5169, 332–338. [Google Scholar] [CrossRef]
- Pierozan, M.K.; Pauletti, G.F.; Rota, L.; dos Santos, A.C.A.; Lerin, L.A.; di Luccio, M.; Mossi, A.J.; Atti-Serafini, L.; Cansian, R.L.; Oliveira, J.V. Chemical characterization and antimicrobial activity of essential oils of salvia L. species. Ciência e Tecnologia de Alimentos 2009, 29, 764–770. [Google Scholar] [CrossRef] [Green Version]
- Lee, S.B.; Cha, K.H.; Kim, S.N.; Altantsetseg, S.; Shatar, S.; Sarangerel, O.; Nho, C.W. The antimicrobial activity of essential oil from Dracocephalum foetidum againsts Pathogenic microorganism. J. Microbiol. 2007, 45, 53–57. [Google Scholar] [PubMed]
- Celaya, L.S.; Alabrudzińska, M.H.; Molina, A.C.; Viturro, C.I.; Moreno, S. The inhibition of methicillin-resistant Staphylococcus aureus by essential oils isolated from leaves and fruits of Schinus areira depending on their chemical compositions. Acta Biochim. Pol. 2014, 61, 41–46. [Google Scholar] [CrossRef] [PubMed]
- Estevez-Areco, S.; Guz, L.; Candal, R.; Goyanes, S. Development of Insoluble PVA Electrospun Nanofibers Incorporating R-Limonene or β-Cyclodextrin/R-Limonene Inclusion Complexes. J. Polym. Environ. 2022, 1–12. [Google Scholar] [CrossRef]
- Aytac, Z.; Yildiz, Z.I.; Kayaci-Senirmak, F.; San Keskin, N.O.; Kusku, S.I.; Durgun, E.; Tekinay, T.; Uyar, T. Fast-Dissolving, Prolonged Release, and Antibacterial Cyclodextrin/Limonene-Inclusion Complex Nanofibrous Webs via Polymer-Free Electrospinning. J. Agric. Food Chem. 2016, 64, 7325–7334. [Google Scholar] [CrossRef] [PubMed]
- Alavi, M. Modifications of microcrystalline cellulose (MCC), nanofibrillated cellulose (NFC), and nanocrystalline cellulose (NCC) for antimicrobial and wound healing applications. E-Polymers 2019, 19, 103–119. [Google Scholar] [CrossRef]

| Sample ID | PVA (10%) | Psyllium Husk (1%) | mMCC Amount (%) | D-Limonene Amount (%) |
|---|---|---|---|---|
| PP0 | 4 | - | - | - |
| PP1 | 4 | 1 | - | - |
| PPD | 4 | 1 | - | 2 |
| PPM | 4 | 1 | 0.012 | - |
| PPMD2 | 4 | 1 | 0.012 | 2 |
| PPMD4 | 4 | 1 | 0.012 | 4 |
| PPMD6 | 4 | 1 | 0.012 | 6 |
| Bacteria | Zone Inhibition (mm) | ||||||
|---|---|---|---|---|---|---|---|
| PP0 | PP1 | PPM | PPD | PPMD2 | PPMD4 | PPMD6 | |
| E. coli | - | - | 8 | 9 | 12 | 18 | 21 |
| S. aureus | - | - | 8 | 9 | 11 | 13 | 16 |
| P. aeruginosa | - | - | 8 | 9 | 11 | 13 | 15 |
Publisher’s Note: MDPI stays neutral with regard to jurisdictional claims in published maps and institutional affiliations. |
© 2022 by the authors. Licensee MDPI, Basel, Switzerland. This article is an open access article distributed under the terms and conditions of the Creative Commons Attribution (CC BY) license (https://creativecommons.org/licenses/by/4.0/).
Share and Cite
Parın, F.N.; Ullah, A.; Yeşilyurt, A.; Parın, U.; Haider, M.K.; Kharaghani, D. Development of PVA–Psyllium Husk Meshes via Emulsion Electrospinning: Preparation, Characterization, and Antibacterial Activity. Polymers 2022, 14, 1490. https://doi.org/10.3390/polym14071490
Parın FN, Ullah A, Yeşilyurt A, Parın U, Haider MK, Kharaghani D. Development of PVA–Psyllium Husk Meshes via Emulsion Electrospinning: Preparation, Characterization, and Antibacterial Activity. Polymers. 2022; 14(7):1490. https://doi.org/10.3390/polym14071490
Chicago/Turabian StyleParın, Fatma Nur, Azeem Ullah, Ayşenur Yeşilyurt, Uğur Parın, Md. Kaiser Haider, and Davood Kharaghani. 2022. "Development of PVA–Psyllium Husk Meshes via Emulsion Electrospinning: Preparation, Characterization, and Antibacterial Activity" Polymers 14, no. 7: 1490. https://doi.org/10.3390/polym14071490






